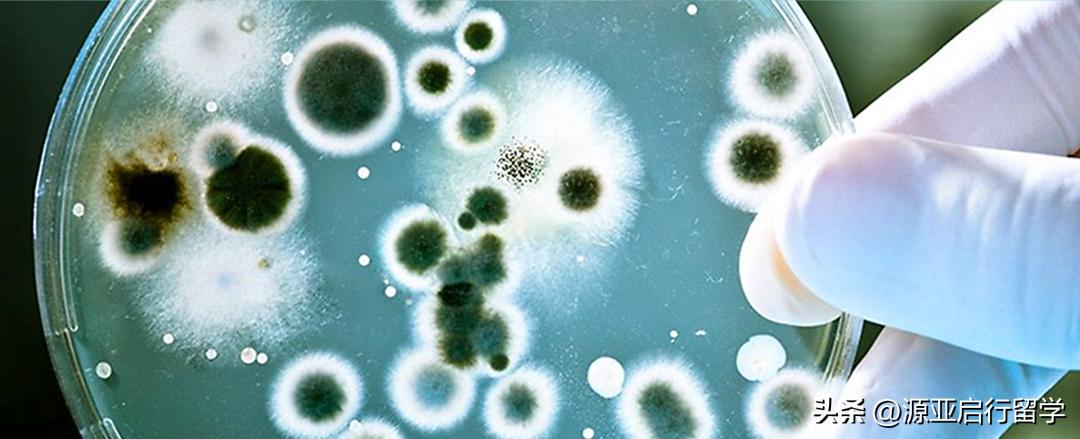
英属哥伦比亚大学硕士留学条件,英属哥伦比亚大学硕士条件

英属哥伦比亚大学( Universityof BritishColumbia ,简称 UBC )创办于 1915 年,是一所世界知名的公立综合类研究型大学,常年稳居 QS 世界大学排名前 50 。该校是多个教育组织的成员,包括全球大学高研院联盟,加拿大U15研究型大*联学**盟、环太平洋大*联学**盟、Universitas21等。
历届以来,UBC涌现了众多知名校友,例如诺贝尔经济学奖得主丹尼尔卡尼曼、诺贝尔物理学奖得主伯特伦 · 布罗克豪斯、中国工程院院士周福霖等。

英属哥伦比亚大学的强势学科有地理学、语言学、环境科学、教育学、心理学、经济学、金融学、计算机科学、数据科学、医学等。以下为部分学科排名情况:
2024QS 学科 ( 世界排名 )- 地理学 9
2024QS 学科 ( 世界排名 )- 语言学 11
2024QS 学科 ( 世界排名 )- 环境科学 12
2024QS 学科 ( 世界排名 )- 护理学 13
2024QS 学科 ( 世界排名 )- 教育与培训 17
2024QS 学科 ( 世界排名 )- 艺术与人文 18
2024QS 学科 ( 世界排名 )- 英语语言与文学 17
2024QS 学科 ( 世界排名 )- 心理学 19
2024QS 学科 ( 世界排名 )- 经济与计量经济学 21
2024QS 学科 ( 世界排名 )- 自然科学 22
2024QS 学科 ( 世界排名 )- 计算机科学与信息系统 26
2024QS 学科 ( 世界排名 )- 会计与金融学 26
2024QS 学科 ( 世界排名 )- 数学 33
2024QS 学科 ( 世界排名 )- 数据科学 42
2024QS 学科 ( 世界排名 )- 医学 27
UBC 设有温哥华和奥肯那根两个校区。以下为两个校区的2025 年 1 月 /5 月入学的硕士项目推荐。
01 UBC 温哥华校区
** 申请 UBC 硕士项目,国内本科学生一般要求双非背景 GPA85% 及以上, 211 背景 GPA80% 及以上。
MASTEROF SCIENCE IN BIOCHEMISTRY AND MOLECULAR BIOLOGY
生物化学与分子生物学理学硕士
生物化学与分子生物学研究生课程提供先进的研究型教育,为学生在不列颠哥伦比亚省及其他地区从事学术、工业或专业工作做好准备。课程主题包括蛋白质结构与功能、基因调控、表观遗传学、膜结构与功能、细胞调控和生物信息学。
项目时长:2-3年
申请时间:2025年1月入学-国际生2024.5.15截止
学术要求:大学本科,相关背景
语言要求:托福不低于106(口语24/写作91/阅读27/听力27),或雅思不低于7.5(7.0)
GRE 成绩:非加拿大/美国学历的申请人需提交
MASTEROF SCIENCE IN BIOINFORMATICS
生物信息学理学硕士
生物信息学理学硕士是一门跨学科课程,将计算机技术应用于生物数据的管理和分析。该硕士课程士旨在培养学生组织、可视化、分析和解释生物数据的能力。学生有机会与英属哥伦比亚大学、西蒙弗雷泽大学和英属哥伦比亚省癌症机构的世界知名生物信息学家面对面交流,并接触到最新技术。
项目时长:2年
申请时间:2025年1月入学-国际生2024.8.15截止
学术要求:申请者必须拥有生命科学学位,并在定量科学方面拥有丰富经验。或者拥有计算机科学/数学/工程学/物理学学位,并在生命科学方面拥有丰富经验。如果学位不属于上述领域,工作经验也可考虑。
语言要求:托福不低于100(口语21/写作21/阅读22/听力22),或雅思不低于7(6)
GRE 成绩:不要求
MASTEROF APPLIED SCIENCE IN BIOMEDICAL ENGINEERING
生物医学工程应用科学硕士
该硕士课程为学生提供生物医学工程基础方面的培训,并在生物力学、生物材料、生化处理、细胞工程、成像、医疗设备、微机电植入系统、生理建模、模拟、监测和控制以及医疗机器人学方面提供广泛的研究经验。
项目时长:2年
申请时间:2025年1月入学-国际生2024.6.1截止
学术要求:大学本科,相关背景
语言要求:托福不低于93(口语21/写作21/阅读22/听力22),或雅思不低于6.5(6)
GRE 成绩:不要求
MASTEROF SCIENCE IN CHEMISTRY
化学理学硕士
UBC温哥华校区的化学系作为世界领先的化学系之一,研究领域涉及分析化学、生物与药物化学、催化过程、化学物理、化学合成、环境化学、材料与聚合物化学、核与放射化学等。
项目时长:2年
申请时间:2025年1月入学-国际生2024.7.31截止
学术要求:大学本科,相关背景
语言要求:托福不低于92(口语22/写作22/阅读23/听力23),或雅思不低于6.5(6)
GRE 成绩:选择提交
MASTEROF APPLIED SCIENCE IN CHEMICAL AND BIOLOGICAL ENGINEERING
化学与生物工程学应用科学硕士
项目时长:2年
申请时间:2025年1月入学-国际生2024.8.1截止
学术要求:大学本科,相关背景
语言要求:托福不低于90(口语21/写作21/阅读22/听力22),或雅思不低于6.5(6)
GRE 成绩:不要求
MASTEROF SCIENCE IN ZOOLOGY
动物学理学硕士
UBC 温哥华校区的动物学系是加拿大实力最强、基础最广泛的生命科学系之一,其研究范围涵盖分子、细胞、整个生物体、种群和群落。该系的教师都是各自领域的领军人物,包括伦敦皇家学会院士、美国国家科学院院士、加拿大皇家学会院士、加拿大研究讲座教授等。
项目时长:2年
申请时间:2025年1月入学-国际生2024.7.15截止
学术要求:大学本科,相关背景
语言要求:托福不低于97(22),或雅思不低于6.5(6)
GRE 成绩:不要求
MASTEROF SCIENCE IN GEOPHYSICS
地球物理学理学硕士
项目时长:2-3年
申请时间:2025年1月入学-国际生2024.6.15截止
学术要求:大学本科,相关背景
语言要求:托福不低于100(口语23,其余22),或雅思不低于7.0(口语7.0,其余6.5)
GRE 成绩:不要求
MASTEROF APPLIED SCIENCE IN GEOPHYSICS
地球物理学应用科学硕士
项目时长:2年
申请时间:2025年1月入学-国际生2024.6.15截止
学术要求:大学本科,相关背景
语言要求:托福不低于100(口语23,其余22),或雅思不低于7.0(口语7.0,其余6.5)
GRE 成绩:不要求
MASTEROF SCIENCE IN GEOLOGICAL SCIENCES
地质科学理学硕士
UBC温哥华校区的地球、海洋和大气科学系地质科学研究涉及实地研究(如矿床研究、火山学、沉积学、构造学、岩石学、水文地质学)、实验研究(如水力压裂、岩石变形、火山过程、二氧化碳封存)和实验室分析(如岩相学、岩石学、地质年代学)。
项目时长:2-3年
申请时间:2025年1月入学-国际生2024.6.15截止
学术要求:大学本科,相关背景,国内双非院校均分85%及以上,国内211院校均分80%及以上
语言要求:托福不低于100(口语23,其余22),或雅思不低于7.0(口语7.0,其余6.5)
GRE 成绩:不要求
MASTEROF APPLIED SCIENCE IN GEOLOGICAL ENGINEERING
地质工程应用科学硕士
该硕士课程结合岩土工程学、水文地质学和地质学的原理,提供跨学科的经验,让学生掌握解决工程与地球环境相互作用相关的各种实际问题所需的多方面技能。
项目时长:2-3年
申请时间:2025年1月入学-国际生2024.6.15截止
学术要求:大学本科,相关背景
语言要求:托福不低于100(口语23,其余22),或雅思不低于7.0(口语7.0,其余6.5)
GRE 成绩:不要求
MASTEROF URBAN DESIGN
城市设计硕士
城市设计硕士课程为期一年,主要侧重于各种规模的城市设计 -- 从地区到街区。Post-professional学习课程将设计工作室与城市设计历史和理论、经济学和公共政策课程相结合。课程结构中,学生有机会通过选修课和研究课题来协调个人对该学科的兴趣。
项目时长:1年
申请时间:2025年5月入学-国际生2024.12.1截止
学术要求:申请者需要拥有建筑学、景观建筑学或规划本科学位。
语言要求:托福不低于90(口语/写作21,听力/阅读22),或雅思不低于6.5(6.0)
GRE 成绩:不要求
MASTEROF SCIENCE IN PLANT SCIENCE
植物科学理学硕士
项目时长:2-3年
申请时间:2025年1月入学-国际生2024.6.1截止
学术要求:大学本科,相关背景
语言要求:托福不低于90(口语/写作21,听力/阅读22),或雅思不低于6.5(6.0)
GRE 成绩:不要求
MASTEROF SCIENCE IN MICROBIOLOGY AND IMMUNOLOGY
微生物学与免疫学理学硕士
该硕士课程包括对细菌、真菌、病毒、寄生虫以及免疫系统的研究。学生可以研究微生物的生态、进化和环境、微生物引起的疾病、微生物组及其对免疫系统和健康、免疫力和疾病的影响。研究涵盖群体和系统生物学与生态学、生物体行为与功能以及细胞相互作用与分子机制。
项目时长:2年
申请时间:2025年5月入学-国际生2024.11.30截止
学术要求:大学本科,相关背景
语言要求:托福不低于100(25),或雅思不低于7.0(6.5)
GRE 成绩:不要求
MASTEROF APPLIED SCIENCE IN MATERIALS ENGINEERING
材料工程应用科学硕士
UBC 温哥华校区材料工程系的材料研究重点是开发新工艺和工艺模型,主要用于运输领域的新型材料和医疗应用领域的生物材料,旨在提供具有社会意义的材料工艺解决方案,包括轻质材料、更清洁和更环保的冶金工艺、替代或修复受伤身体部位的工程材料。该系通过其工业研究教席促进与工业界的紧密互动。
项目时长:1-2年
申请时间:2025年1月入学-国际生2024.8.1截止
学术要求:大学本科,相关背景
语言要求:托福不低于90(口语/写作21,听力/阅读22),或雅思不低于6.5(6.0)
GRE 成绩:不要求
MASTEROF SCIENCE IN MATERIALS ENGINEERING
材料工程理学硕士
UBC 温哥华校区材料工程系的材料研究重点是开发新工艺和工艺模型,主要用于运输领域的新型材料和医疗应用领域的生物材料,旨在提供具有社会意义的材料工艺解决方案,包括轻质材料、更清洁和更环保的冶金工艺、替代或修复受伤身体部位的工程材料。该系通过其工业研究教席促进与工业界的紧密互动。
项目时长:2年
申请时间:2025年1月入学-国际生2024.8.1截止
学术要求:大学本科,相关背景
语言要求:托福不低于90(口语/写作21,听力/阅读22),或雅思不低于6.5(6.0)
GRE 成绩:不要求
MASTEROF LAWS (COMMON LAW)
法律硕士(普通法)
普通法法学硕士课程为期一年,为外国法律专业毕业生提供加拿大普通法体系的基础培训。没有接受过正规普通法培训的申请人,如接受过大陆法培训或来自混合法律传统的申请人,必须在五月份开始学习加拿*法大**学硕士课程。在五月份开课,学生可以先完成一些加拿大普通法的基础课程,然后再参加九月份的高级研究生或高年级法学博士课程。
项目时长:1年
申请时间:2025年5月入学-国际生2024.10.15截止
学术要求:申请者必须持有或正在完成法学学士学位。
语言要求:托福不低于100(口语21,其余25),或雅思不低于7.0(阅读/写作7.0,口语/听力6.5)
GRE 成绩:不要求
LLMIN TAXATION
税务法学硕士
税务法学硕士是一个为期 1 年的全日制非论文学位,也可选择非全日制。对于大多数全日制学生来说,完成课程要求需要两个学期,加上7月至8月的必修入门强化课程。
项目时长:1年
申请时间:2025年7月入学-国际生2024.11.1截止
学术要求:申请者拥有法学博士或法学学士学位;或相关本科学位、优异成绩以及在税务领域有丰富工作经验。
语言要求:托福不低于100(口语21,其余25),或雅思不低于7.0(阅读/写作7.0,口语/听力6.5)
GRE 成绩:不要求
02 奥肯纳根校区
** 申请 UBC 硕士项目,国内本科学生一般要求双非背景 GPA85% 及以上, 211 背景 GPA80% 及以上。奥肯纳根校区大部分硕士项目对大三和大四专业课成绩有更高要求。
MScin Chemistry
化学硕士

项目时长:2年
申请时间:
2025年1月入学-国际生2024.6.1截止
2025年5月入学-国际生2024.10.20截止
学术要求:大学本科,化学或相关专业
语言要求:托福不低于90(口语/写作21,听力/阅读22),或雅思不低于6.5(6.0)
GRE 成绩:不要求
MScin Earth and Environmental Sciences
地球与环境科学理学硕士

项目时长:2年
申请时间:
2025年1月入学-国际生2024.6.1截止
2025年5月入学-国际生2024.10.13截止
学术要求:大学本科,地球与环境科学或相关专业
语言要求:托福不低于90(口语/写作21,听力/阅读22),或雅思不低于6.5(6.0)
GRE 成绩:不要求
MAin Education
教育学文学硕士

项目时长:2-2.5年
申请时间:
2025年1月入学-国际生2024.6.1截止
2025年5月入学-国际生2024.10.15截止
学术要求:大学本科,2年教学经验
语言要求:托福不低于90(口语/写作21,听力/阅读22),或雅思不低于6.5(6.0)
GRE 成绩:不要求
MScin Mathematics
数学理学硕士

项目时长:2年
申请时间:2025年1月入学-国际生2024.6.1截止
学术要求:大学本科,数学或相关专业
语言要求:托福不低于90(口语/写作21,听力/阅读22),或雅思不低于6.5(6.0)
GRE 成绩:不要求
MScin Biochemistry and Molecular Biology
生物化学和分子生物学理学硕士

项目时长:2年
申请时间:
2025年1月入学-国际生2024.6.1截止
2025年5月入学-国际生2024.10.13截止
学术要求:大学本科,生物化学、化学、生物学或相关专业
语言要求:托福不低于90(口语/写作21,听力/阅读22),或雅思不低于6.5(6.0)
GRE 成绩:不要求
MScin Biology
生物学理学硕士
项目时长:2年
申请时间:
2025年1月入学-国际生2024.6.1截止
2025年5月入学-国际生2024.9.25截止
学术要求:大学本科,生物学或相关专业
语言要求:托福不低于90(口语/写作21,听力/阅读22),或雅思不低于6.5(6.0)
GRE 成绩:不要求
奥肯纳根校区工程学院
MASc 学位:硕士课程和论文 18-24 个月
MDes 学位:工程学硕士课程 12 个月(仅课程)
Meng 学位:工程硕士课程 12 个月(仅课程)或 16-24 个月(含实习)
研究领域

申请时间:
2025年1月入学-国际生2024.6.1截止
2025年5月入学-国际生2024.10.1截止
学术要求:大学本科,工程类相关专业
语言要求:托福不低于90(口语/写作21,听力/阅读22),或雅思不低于6.5(6.0)
GRE 成绩:不要求
MScin Computer Science
计算机科学理学硕士

项目时长:2年
申请时间:2025年1月入学-国际生2024.6.1截止
学术要求:大学本科,计算机科学或相关专业
语言要求:托福不低于90(口语/写作21,听力/阅读22),或雅思不低于6.5(6.0)
GRE 成绩:不要求